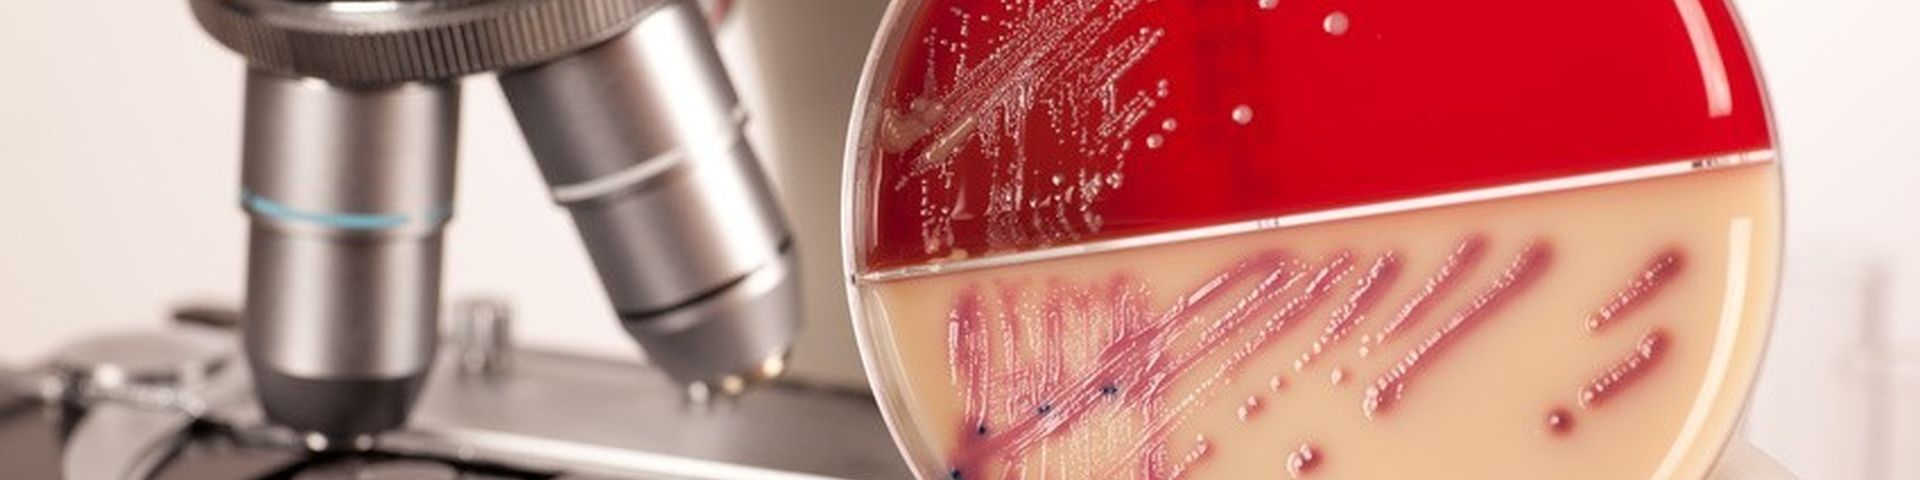

Pilzerkrankung
PILZE KÖNNEN FAST ÜBERALL ENTSTEHEN
Pilzerkrankungen, die so genannten Mykosen, der Haut und der Nägel zählen zu den häufigsten Infektionskrankheiten unserer Zeit.
Etwa 30-50 % der Erwachsenen leiden unter Fußpilz; einen Nagelpilz hat etwa jeder Achte. In der Regel sind Pilzinfektionen an den Händen und Füßen harmlos, da die Erreger nicht die Schleimhäute oder inneren Organe befallen.
Eine Behandlung ist trotzdem wegen der hohen Ansteckungsgefahr sehr wichtig. Außerdem heilen diese lokalen Infektionen nicht von alleine aus. Sie können sogar Ausgangspunkt für Infektionen der gesamten Hautoberfläche und des behaarten Kopfes werden.
